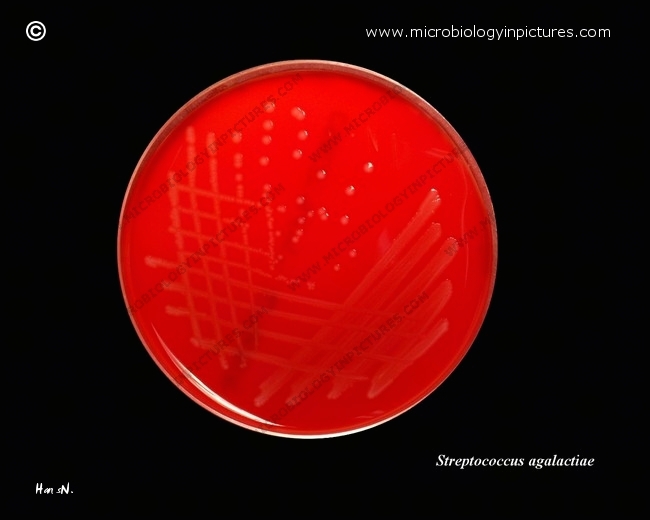

Streptococcus agalactiae (GBS) cultivated on Columbia agar with 5% defibrinated sheep blood.
Cultivation 24 hours in an aerobic atmosphere enriched with 5% carbon dioxide.
Isolated colonies in this strain are practically without visible zones of beta-hemolysis.